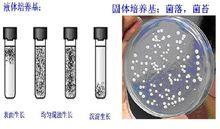
半強度MS液體培養基

培養技巧
組織培養是否能夠獲得成功,主要取決於對培養基的選擇。不同的培養基具有不同的特點,也就適合於不同的植物種類和接種材料。在開展組織培養項目時,首先要對各種培養基進行了解和分析,以便能從中選擇合適的使用。組培用的培養基一般包括基礎培養基和激素,但是植物激素的種類和數量,隨著不同培養階段和不同材料有變化,因此各培養基配方中均不列入植物激素。常用的基礎培養基有ms培養基,B5培養基,N6培養基。
MS培養基是目前使用最普遍的培養基。其具有較高的無機鹽濃度,能夠保證組織生長所需的礦質營養還能加速愈傷組織的生長。由於配方中的離子濃度高,在配製、貯存和消毒等過程中,即使有些成分略有出入,也不會影響離子間的平衡。MS固體培養基可用於誘導愈傷組織,也可用於胚、莖段、莖尖及花葯的培養,其液體培養基用於細胞懸浮培養時能獲得明顯的成功。MS培養基的無機養分的數量和比例比較合適,足以滿足植物細胞在營養上和生理上的需要。因此,一般情況下,不用再添加胺基酸、酪蛋白水解物、酵母提取物及椰子汁等有機附加成分。和其它培養基的基本成分相比,MS培養基中的硝酸鹽、鉀和銨的含量高,這是它的顯著特點。
愈傷組織不能進行光合作用。在植物的組織培養中,從一塊外植體形成典型的愈傷組織,大致要經歷三個時期:啟動期、分裂期和形成期。啟動期指細胞準備進行分裂的時期。外源植物生長激素對誘導細胞開始分裂效果很好。常用的有萘乙酸、吲哚乙酸、細胞分裂素等。通常使用細胞分裂素和生長素比例在1:l來誘導植物材料愈傷組織的形成。分裂期是指外植體細胞經過誘導以後脫分化,不斷分裂、增生子細胞的過程。分裂期愈傷組織的特點是:細胞分裂快,結構疏鬆,顏色淺而透明。分化期是指在分裂的末期,細胞內開始出現一系列形態和生理上的變化,從而使愈傷組織內產生不同形態和功能的細胞。這些細胞類型有薄壁細胞、分生細胞、色素細胞、纖維細胞等等。外植體的細胞經過啟動、分裂和分化等一系列變化,形成了無序結構的愈傷組織。如果在原來的培養基上繼續培養愈傷組織,會由於培養基中營養不足或有毒代謝物的積累,導致愈傷組織停止生長,甚至老化變黑、死亡。如果要讓愈傷組織繼續生長增殖,必須定期地(2~4個星期)將它們分成小塊“接種到新鮮的培養基上,這樣愈傷組織就可以長期保持旺盛的生長。
指培養基(Medium)是供微生物、植物和動物組織生長和維持用的人工配製的養料,一般都含有碳水化合物、含氮物質、無機鹽(包括微量元素)以及維生素和水等。有的培養基還含有抗菌素和色素,用於單種微生物培養和鑑定。
愈傷組織細胞在一種包含所有必需物質的培養基中培養了幾個小時,其中一種化合物具有放射性(氚標記)當這些細胞被固定後鏡檢,利用放射自顯影技術發現放射性物質集中於細胞核、線粒體和葉綠體,可以肯定標記的化合物是胸腺嘧啶脫氧核苷酸。
水稻愈傷
在外植體上形成以後,愈傷組織的繼承培養在已充分發育,但沒有出現老化現象之前,應及時從外植體上分離下來,轉入繼代培養基上進行繼代培養。分離是必要的措施,繼代培養時若連同外植體就會影響愈傷組織的產量和質量,可能是由於殘存的外植體在死亡過程中會產生某些有毒物質,愈傷組織會出現老化、粘化及不正常分化等現象。一般情況下,從外植體上分離的愈傷組織須經過4~6周的培養才能得到充分的發育。為了增殖發育良好的愈傷組織,繼代培養是有效的措施。在良好的培養條件下,甘蔗愈傷組織可繼代一年以上而不喪失分化能力。
半強度MS液體培養基
半強度MS液體培養基影響甘蔗愈傷組織繼代培養的主要因素是激素。為協調繼代培養中既要維持愈傷組織增殖生長良好、又要保持愈傷組織的分化能力的矛盾,就必須篩選最佳的激素濃度。有報導指出,2,4-D(2~3mg/L)對保持愈傷組織不分化是有效的,但隨繼代培養次數的增加,其分化綠苗的能力也隨之下降。

